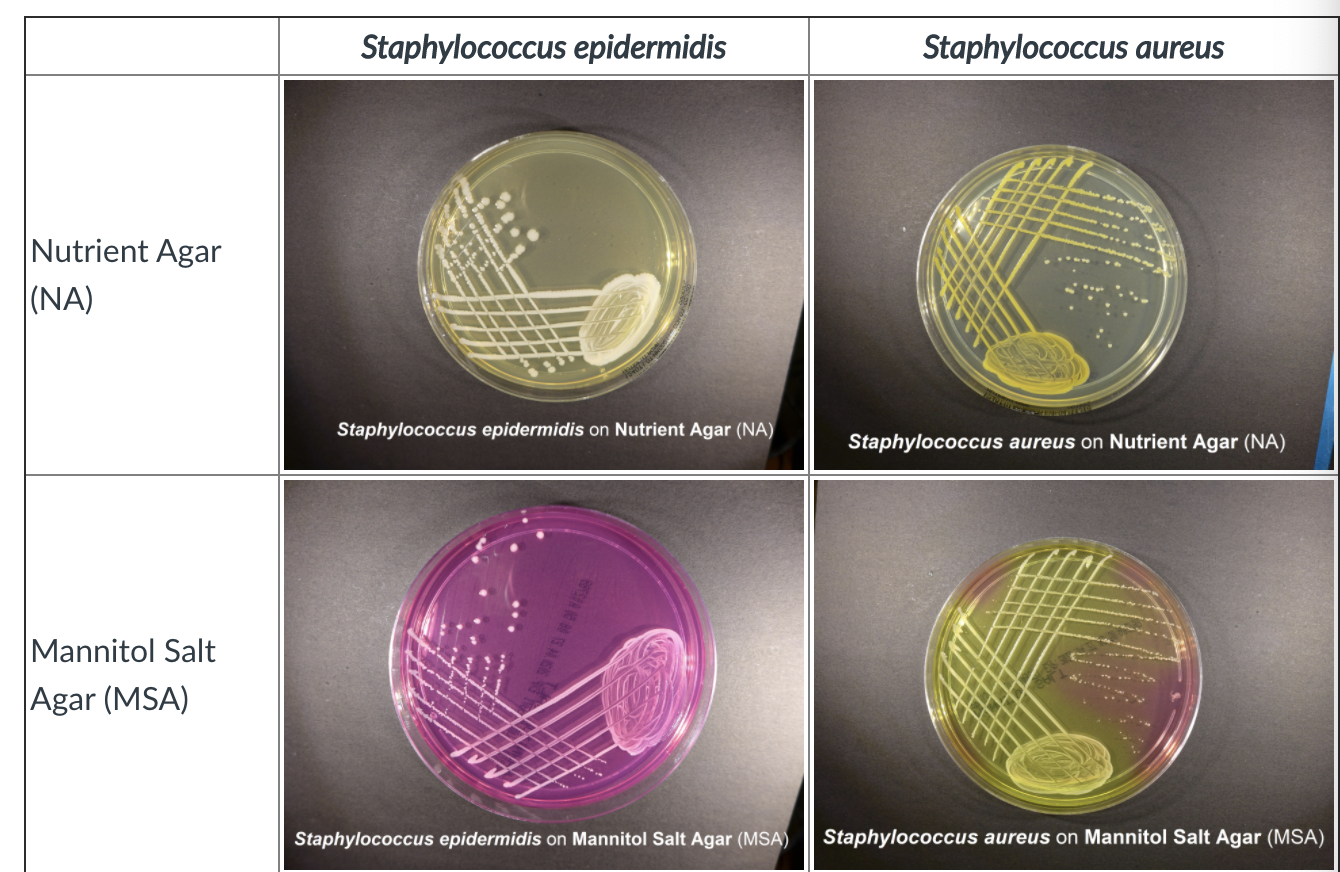
Solved Scientific Name Of Microorganism Pseudomonas Pseu Chegg Com

Msa plate staphylococcus aureus 268065-Msa plate staphylococcus aureus
· Mannitol Salt Agar (MSA) is used as a selective and differential medium for the isolation and identification of Staphylococcus aureus from clinical and nonclinical specimensSee the answer FILL IN THE BLANKS WITH THE RESULT GIVEN Show transcribed image text Expert Answer A MannitolSalt Agar (MSA)MSA is selective for gram organisms (inhibits g) What is MSA (mannitol

Prevalence Of Methicillin Resistant Staphylococcus Aureus In Shrines
Msa plate staphylococcus aureus
Msa plate staphylococcus aureus-Tryptic soy agar (TSA) inoculated with (A) Staphylococcus aureus, (B) Staphylococcus epidermidis, and (C) Escherichia coli demonstrating growth of all three organismsMSA contains phenol red as a pH indicator which is used to detect acid produced by mannitolfermenting staphylococci at pH levels below 69, Staphylococcus aureus produces yellow colonies with yellow zones, whereas other coagulasenegative staphylococci produce small pink or red colonies with no color change to the medium If an organism can ferment mannitol, an acidic



Staphylococcus Aureus An Overview Microbe Notes
2502 · Mannitol salt agar plates protocols Tryptic soy agar (TSA) inoculated with (A) Staphylococcus aureus, (B) Staphylococcus epidermidis, and (C) Escherichia coli demonstrating growth of all three organisms TSA is a general purpose medium that will allow for the growth of all three organisms In this way, which organisms did not grow on MSA plate?After incubation, the MSA plate displayed isolated colonies and turned yellow demonstrating Mannitol fermentation Relying on the results from this MSA plate and a positive Nitrate result led to an initial deduction of Staphylococcus aureus Mannitol broth was then inoculated with the Grampositive bacteria and a negative result was achieved This led to further testing of Methyl Red · Mannitol Salt Agar (MSA) is a selective media used for isolation, enumeration and differentiation of pathogenic Staphylococci spp from samples ranging in the clinical, food, antiseptic, and cosmetic testing industries
MSA is differential for mannitol fermentation (Saureus) What is MSA (mannitol salt agar) differential for?In the previous lab, BAP and MSA plates were inoculated with Staphylococcus and Streptococcus spp Blood agar is a rich, nonselective medium that supports the growth of most bacteria However, it is differential based on the ability of the organism to produce enzymes called hemolysins, which lyse red blood cells (RBC) Three patterns of hemolysis can be observed on a blood agar plateOn MSA plates were in fact isolates of S aureus Two hundred seven reports were reviewed, and it was found that in 98% of cases, if yellow colonies were found at quantities of 1 (1 is defined as growth only in the first quadrant of streaking) on the MSA plate, then the
2) Name three characteristics of a coliform 3) Name two differences between adaptive and innate immunity 4) What is the function ofThe MSA plate is a reliable test tool selective for staphylococci 17 because it contains 75% NaCl, which suppresses the growth of other bacteria, thereby allowing Staphylococcus sp to grow more readily 17,18 Mannitol salt agar also contains mannitol, which is metabolized by Staphylococcus aureus but not by other species of Staphylococcus, thus allowing for differentiation of StaphylococcusA useful selective medium for recovering Staphylococcus aureus from faecal specimens when investing food poisoningIt can be used to screen for nasal carri



Mannitol Salt Bacterial Growth Medium Msa Page 2



Microbiology And Beauty What Has Been Made
26 · Mannitol Salt Agar (MSA) is a selective and differential medium Most pathogenic staphylococci, such as Staphylococcus aureus, will ferment mannitol Most nonpathogenic staphylococci will not ferment mannitol The Staphylococcus aureus ferments mannitol and turns the medium yellowA mannitol salt agar test is used to isolate and identify the presence of Staphylococcus aureus in a clinical specimen, which makes it both a selective, differential, and indicator medium Picture 1 Mannitol salt agar test as a part of a selective medium On the left side grows Staphylococcus aureus and no growth took side on the right side · Suppose that you streak a MSA plate with Staphylococcus aureus and incubate the plate at 37 C for 2436 hours Describe the expected appearance of the agar after incubation agar (or the region of the agar near growth) should turn yellow Suppose that you streak a MSA plate with Staphylococcus epidermidis and incubate the plate at 37 C for 2436 hours Describe the



Exercise 51 Staphylococci Flashcards Quizlet



How To Interpret Mannitol Salt Agar Bacterial Growth Medium Youtube
The gram positive cocci were identified after first isolating the medium on to a Mannitol Salt Agar (MSA) plate Then it was inoculated in BCP Mannitol broth The color change to yellow indicated acid production by Mannitol fermentation This indicated that the unknown was Staphylococcus aureus or Enterococcus faecalisStaphylococcus epidermidis grows on MSA, but does not ferment mannitol (media remains light pink in color, colonies are colorless) Considering this, can E coli grow on MSA?Staphylococcus other than S aureus (does not ferment mannitol) What is the result for streak B on this MSA plate?


Experiment 8c Lab08 Virtual Edge Molb 21 College Of Agriculture And Natural Sciences



Antibiotic Resistance Pattern Of Staphylococcus Aureus With Reference To Mrsa Isolates From Pediatric Patients Future Science Oa
Staphylococcus aureus Example of an organism that would be negative for mannitol fermentation on an MSA plate Staphylococcus epidermis Example of an organism that is positive for lactose fermentation on a MacConkey plate E coli Example of an organism that is negative for lactose fermentation on a MacConkey plate Pseudomonas Aeruginosa Example of an organism thatS aureus is a facultatively anaerobic, Grampositive coccus, which appears as grapelike clusters when viewed through a microscope, and has round, usually goldenyellow colonies, often with hemolysis, when grown on blood agar plates The golden appearance is the etymological root of the bacterium's name;Expected colony characteristics of



Golden Yellow Colonies Of Staphylococcus Aureus On Msa Download Scientific Diagram



Staphylococcus Aureus Staphylococcus Epidermidis Streptococcus Pneumoniae And Streptococcus Pyogenes On Mannitol Salt Agar Plates Containing Ppt Download
Staphylococcus aureus and Staphylococcus epidermidis on mannitol salt agar Mannitol salt agar is a commonly used growth medium in microbiology It encourages the growth of a group of certain bacteria while inhibiting the growth of othersMSA supplemented with 1·5 mg l −1 acriflavine was tested for selective growth of indigenous S aureus from three grab samples of FDMW Acriflavine concentrations of 1·5 mg l −1 reduced background flora without significantly reducing (P(Growth Or No Growth) Describe The Color This problem has been solved!


Staphylococcus Aureus And Staphylococcus Epidermidis On Mannitol Salt Agar Mannitol Salt Agar Composition Positive And Negative Result On Mannitol Salt Agar



Typical Golden Yellow Colonies Of Staphylococcus Aureus On Mannitol Download Scientific Diagram
Beside this, what Bacteria grows on MSA?Aureus meaning "golden" in Latin Staphylococcus epidermidis showing γhaemolytic, porcelinwhite colonies as compared to S aureus on the same medium This clearStaphylococcus aureus, a pathogenic mannitol fermenter Right plate growing nonmannitol fermenter S epidermidis Click here for more images of Mannitol Salt Agar



Metabolism Physiology And Growth Characteristics Of Cocci Microbiology A Laboratory Experience



Mannitol Salt Agar Msa Test Scientist Cindy
Homework for Portfolio 43 1) What are the results for Staphylococcus aureus for MSA plate and coagulase test?Staphylococcus aureus and Staphylococcus epidermidis on mannitol salt agar Mannitol salt agar is a commonly used growth medium in microbiology It encourages the growth of a group of certain bacteria while inhibiting the growth of others which organisms did not grow on MSA plate?MSA also contains the sugar mannitol and the pH indicator phenol red If an organism can ferment mannitol, an acidic byproduct is formed that will cause the phenol red in the agar to turn yellow Most pathogenic staphylococci, such as Staphylococcus aureus, will ferment mannitol Most nonpathogenic staphylococci will not ferment mannitol



Mic 224 Lab 7 Selective And Differential Media I Msa Sba Sta And Gel Ppt Download



Mannitol Salt Agar Wikipedia
2312 · Cultural characteristics of Staphylococcus aureus Staphylococci grow readily on most bacteriologic media under aerobic or microaerophilic conditions Colonies on solid media are round, smooth, raised, and glistening S aureus usually forms gray to deep golden yellow colonies Mannitol Salt Agar circular, 2–3 mm in diameter, with a smooth, shiny surface;Materials Cultures of Staphylococcus aureus and Streptococcus epidermidis Mannitol Salt Agar plate Bunsen burner Inoculating loop Procedure 1 Using a Sharpie, divide plate into two sections and label each with the appropriate organism, your name, and the date 2 Using aseptic technique, streak a small amount of Staphylococcus aureus and Staphylococcus epidermidis on opposite sides of an MSAAn MSA plate with Micrococcus sp (1), Staphylococcus epidermidis (2) and S aureus colonies (3) Mannitol salt agar or MSA is a commonly Mannitol salt agar or MSA is a commonly Remel™ Mannitol Salt Agar (MSA)



Asmscience Mannitol Salt Agar Plates Protocols



Lab Manual Superfarmer S Weblog
Mannitol salt agar Last updated January 29, 21 An MSA plate with Micrococcus sp (1), Staphylococcus epidermidis (2) and S aureus colonies (3) Mannitol salt agar or MSA is a commonly used selective and differential growth medium in microbiologyIt encourages the growth of a group of certain bacteria while inhibiting the growth of othersStaphylococcus aureus produces yellow colonies with yellow zones Coagulasenegative staphylococci (MSA) Plate and will produce colonies However, Staphylococcus epidermidis does not have the ability to ferment mannitol, because it lacks the enzyme coagulase In other words, Staphylococcus epidermis is considered "coagulase " or "coagulasenegative" SinceMannitol salt agar (MSA) is a selective, differential, and indicator medium that is used to isolate and identify Staphylococcus aureus from the clinical specimen Participating reviewers Dexter Beck Chattahoochee Reply According to the biochemical test results, 11 out of 22 retrieved isolates from blood agar and 32 out of 80 isolates from mannitol salt agar were presumptively



Pin On Tasha Sturm Everything Microbiology



Staphylocicci Lecture 3 Staphylococcus Sp Morphology Gram Positive Cocci In Clusters Culture Facultative Anaerobes Incubation 37ºc Ppt Download
Aureus means "golden" in LatinNose and Ear Swab for S aureus Alexander Ogston was a surgeon and bacteriologist most famous for his discovery of Staphylococcus aureus in the year 10 With a great admiration for Joseph Lister and his value of antisepsis, Ogston rejected the belief that the formation of pus was a natural part of the healing processStaph aureus on Mannitol Salt Agar For those in need of highresolution images, we will soon be offering hires files of many photos in the Science Image Library Follow us on Twitter @ScienceProfSPO to get updates on new SPO features and products If you need a high resolution photo now, please contact us


Biol 230 Lab Manual Staphylococcus Aureus On Mannitol Salt Agar



Isolation And Identification Of Staphylococci Gram Stain Gram
PROTOCOL 1 GRAM POSITIVE COCCI Mannitol Salt Agar (MSA) Purpose To isolate bacteria based on their salt tolerance and differentiate among these isolates for mannitol fermentation Materials Cultures of Staphylococcus aureus and Streptococcus epidermidis Mannitol Salt Agar plate Bunsen burner Inoculating loop Procedure MSA is a selective and differential medium · Mannitol salt agar (MSA) is a selective, differential, and indicator medium that is used to isolate and identify Staphylococcus aureus from the clinical specimen Yellow colonies of S aureus in Mannitol Salt Agar (MSA) Mannitol salt agar (MSA) contains Mannitol (1%) Mannitol is one of the major ingredientsPathogenic Staph, such as Staphylococcus aureus, are mannitol fermenters, and when growing on Mannitol Salt Agar, their wastes turn the MSA a bright yellow color PHOTOS OF MANNITOL SALT AGAR (MSA) 1 Sterile plate of Mannitol Salt agar;



Mannitol Salt Agar Microbiology Images Photographs From Science Prof Online



Mannitol Salt Agar Msa Mycrobe
· For the other agar platesSM 110 plate,mannitol salt agar (MSA) plate, DNAse agar plate—an inoculation line down the center of the plate is adequate for growth results Incubate media at 37°C Run oxidase and catalase tests on plate culture Gram stain the isolate to get shape and arrangement as well as gram reactionMannitol Salt Agar (MSA) Plate I Staphylococcus epidermidis (Gram positive) growth but no yellow halo II Escherichia coli (Gram negative) No growth III Staphylococcus aureus (Gram positive) growth with yellow halo IV Psuedomonas aeruginosa (Gram negative) no growth Mannitol Salt Agar (MSA) is used to determine if the bacteria isOn blood agar plates, colonies of Staphylococcus aureus are frequently surrounded by zones of clear betahemolysis The golden appearance of colonies of some strains is the etymological root of the bacteria's name;



A Staphylococcus Aureus And B Staphylococcus Epidermidis On Download Scientific Diagram

Solved Scientific Name Of Microorganism Pseudomonas Pseu Chegg Com
· Staphylococcus aureus is a ubiquitous commensal bacterium on human skins and anterior nares, but frequently causes severe infections in humans Rapid and direct identification of S aureus is crucial for proper management of patients with skin infections, abscesses, septicemia/bacteremia, gastroenteritis, endocarditis, toxic shock syndrome and certain foodSwab 1/2 of the MSA plate with the sweaty skin sample and perform a streak isolation on the rest of the plate using an inoculation loop in the usual fashion 3 Label your plate, invert it and place it in the 37 ºC incubator I will remove the plates in 24 hours to room temperature The heat accelerates the growth, but it is not required for the microbes to grow 4 Examine your plates at theThe differential ingredient in MSA is the sugar mannitol Organisms capable of using mannitol as a food source will produce acidic byproducts of fermentation that will lower the pH of the media The acidity of the media will cause the pH indicator, phenol red, to turn yellow Staphylococcus aureus is capable of fermenting mannitol (left side of left plate) while Staphylococcus epidermidis is



Types Of Culture Media Pptx 2



Isolation Of Foodborne Pathogens On Selective Differential And Enriched Medium By Streak Plating Springerlink
· mannitol salt agar plate (msa) Selective for grampositive bacterium (eg Staphylococcus) Mannitol fermentation by pathogenic staphylococci, such as S aureus and S simulans is indicated by the agar media changing from red to yellowStaph aureus grow on Mannitol Salt Agar About 8 % to 12 % of Staph aureus strains will not ferment mannitol I used to carry a mannitol nonfermenting Staph aureus in my anterior naresAureus Staphylococcus Aureus Streptococcus Mitis (there's A Typo On The Plate) Sllove Dants MSA Plate Organism Was There Growth For This Microbe On The Plate?



Mannitol Salt Agar Microbiology Images Photographs From Science Prof Online



Micro Lab 4 Flashcards Quizlet
Mannitol Salt Agar (MSA) is used as a selective and differential medium for the isolation and identification of Staphylococcus aureus from clinical and nonclinical specimens It encourages the growth of a group of certain bacteria while inhibiting the growth of others It is a selective medium prepared according to the recommendations of Chapman for the isolation of(A) Staphylococcus aureus, (B) Staphylococcus epidermidis, and (C) Escherichia coli streaked on a mannitol salt agar plate The mannitol fermenting colony (yellow) is S aureus, while the mannitol nonfermenting colony (pink) is S epidermidis The growthMannitol fermentation What type of metabolism is happening that makes the media yellow?


Mannitol Salt Agar



Experiment 45 Bacteria Of The Skin Flashcards Quizlet



Ppt Selective And Differential Media Powerpoint Presentation Free Download Id



Asmscience Mannitol Salt Agar



Yellow Colonies Of S Aureus On Mannitol Salt Agar Download Scientific Diagram



Staphylococcus Aureus On Msa Plate Page 1 Line 17qq Com



Growth On Mannitol Salt Agar Media Showing Presence Of Yellow Halo Download Scientific Diagram



Staphylococcus Aureus On Msa Plate Page 4 Line 17qq Com



Mannitol Salt Agar Msa Images Stock Photos Vectors Shutterstock



Enterococcus Faecalis Italic Can Be Distinguished From Italic Enterococcus Faecium Italic Via Differential Susceptibility To Antibiotics And Growth And Fermentation Characteristics On Mannitol Salt Agar



Solved Stoph Epidermidis Mannitol Salt Agar Plate Resul Chegg Com



Pin On Microbiology



Staphylococcus Aureus Colony Morphology And Microscopic Appearance Basic Characteristic And Tests For Identification Of S Aureus Bacteria Images Of Staphylococcus Aureus Antibiotic Treatment Of Staphylococcal Infections



Mannitol Salt Agar Images Stock Photos Vectors Shutterstock



Staphylococcus Aureus On Msa Plate Page 2 Line 17qq Com


Mannitol Salt Agar Chapman Medium Staphylococcus Aureus And Staphylococcus Epidermidis Colonies On Mannitol Salt Agar Plate



Growth Of Staphylococcus Aureus On Mannitol Salt Agar Download Scientific Diagram



Solved Staphylococcus Aureus Staphylococcus Epidermidis M Chegg Com



Mannitol Salt Agar Plate Test Composition Preparation Uses Laboratoryinfo Com


Staphylococcus Mannitol Salt Agar Plate Medical Laboratories



Welcome To Microbugz Mannitol Salt Agar



Solved Mannitol Salt 1 What Is This Media Selective And Chegg Com



Product Catalog



Mannitol Salt Agar Msa Composition Uses And Colony Characteristics Learn Microbiology Online



Pdf Mannitol Salt Agar Semantic Scholar



Mannitol Salt Agar Msa Test Scientist Cindy



I Ve Attached Lab Worksheets And Images Phenylet Chegg Com



Mannitol Salt Agar Plate Microbiology Notes And Updates Facebook



Selective Growth Of Staphylococcus Aureus From Flushed Dairy Manure Wastewater Using Acriflavine Supplemented Mannitol Salt Agar Davis 06 Letters In Applied Microbiology Wiley Online Library



Prevalence Of Methicillin Resistant Staphylococcus Aureus In Shrines



Medical Bacteriology Ppt Video Online Download



Lab 5 Integumentary System Bacteriology And Identification Ppt Download



Solved 2 Fill In The Blanks In This Diagram To Make A Ke Chegg Com



Emb Agar Only Gramnegative Bacteria Grow On Emb



Staphylococci Prac Microbiology



Microbiology Final Lab Practical Flashcards Quizlet



Mannitol Salt Bacterial Growth Medium Msa Page 2



Micro Pf Flashcards Quizlet



Mannitol Salt Agar Images Stock Photos Vectors Shutterstock



Mannitol Salt Agar Msa Composition Uses And Colony Characteristics Learn Microbiology Online



Staphylococcus Epidermidis On Msa Plate Page 1 Line 17qq Com



Staphylococcus Aureus An Overview Microbe Notes



Staphylococcus Aureus An Overview Microbe Notes


Biol 230 Lab Manual Staphylococcus Epidermidis On Mannitol Salt Agar



Mannitol Salt Agar Staphylococcus Aureus Msa Youtube



Photo 40 1 Staphylococcus Aureus Cultured On Mannitol Salt Agar Msa Download Scientific Diagram



Typical Golden Yellow Colonies Of Staphylococcus Aureus On Mannitol Download Scientific Diagram



Mannitol Salt Agar Plate Inoculated With Staphylococcus Aureus Yellow Download Scientific Diagram



S Aureus On Msa Plate Medical Laboratory Science Microbiology Medical Laboratory



Mannitol Salt Agar Msa Results Theory Youtube



Staphylococcus



Mannitol Salt Agar Msa Test Scientist Cindy


Untitled Document



Mannitol Salt Agar Msa Composition Uses And Colony Characteristics Learn Microbiology Online



Mannitol Salt Agar For The Isolation Of Staphylococcus Aureus



Mannitol Salt Agar Msa Test Superfarmer S Weblog


Biomerieux Culture Media Product Mannitol Salt 2 Agar



S Aureus And E Faecalis Colonies Obtained By Culturing Them On Download Scientific Diagram


Mannitol Salt Agar



Staphylococcus Epidermidis On Agar Plate With Mannitol Salt Agar Chapman Agar Growth Of S Epidermidis In Petri Dish On Chapman Agar Medium Appearance And Morphology Of Staphylococcus Epidermidis And S Aureus Colonies On Mannitol


Experiment 8c Lab08 Virtual Edge Molb 21 College Of Agriculture And Natural Sciences



Mannitol Salt Phenol Red Agar For Microbiology Chapman Agar Sigma Aldrich


Staphylococcus On Mannitol Salt Agar



Mannitol Salt Agar Msa Images Stock Photos Vectors Shutterstock



Mannitol Salt Agar Msa Composition Uses And Colony Characteristics Learn Microbiology Online



Solved Mannitol Salt Agar Msa Looking At The Selectiv Chegg Com



Solved Microbiology Question In Lab I Was Given Three U Chegg Com



Pht 313 Lab 1 Staphylococci Bacteria Grams Stain



Staphylococci Flashcards Quizlet


コメント
コメントを投稿